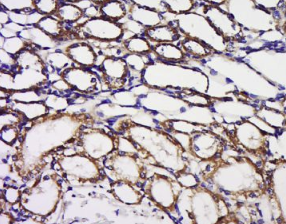

英文名称:Anti-BPNT1
中文名称:二磷酸3核苷酸酶抗体(BPNT1)
抗体来源:兔子
克隆类型:多克隆
交叉反应:人、小鼠、大鼠、牛
产品应用:WB=1:500-2000 ELISA=1:500-1000 IHC-P=1:100-500 IHC-F=1:100-500 ICC=1:100-500 IF=1:100-500(石蜡切片需做抗原修复)
分 子 量:33kDa
细胞定位:细胞浆 细胞外基质
状态:冻干或液体
浓度:1mg/ml
来源于:KLH conjugated synthetic peptide derived from human BPNT1:2-100/308
亚型:IgG
纯化方法:affinity purified by Protein A
储存液:0.01M TBS(pH7.4) with 1% BSA, 0.03% Proclin300 and 50% Glycerol.
别 名:4-phosphatase; Bisphosphate 3 prime nucleotidase; Bpnt1; BPNT1_HUMAN; BPntase; PAP inositol 1,4 phosphatase; PAP-inositol-1; PIP.
保存条件:在-20°C下保存一年。避免反复冻融。冻干抗体在室温下至少稳定一个月,并在-20°C下保持一年以上。当在无菌pH7.4 0.01M PBS或抗体稀释剂中重组时,抗体在2-4°C下至少稳定两周。
产品介绍:
BPNT1是一个镁依赖、锂敏感的磷酸单酯酶超家族成员。以镁为辅因子,BPNT1催化PAP(腺苷3’-磷酸5’磷酸硫酸盐)转化为APS(腺苷5’-磷酸硫酸盐)以及PAP(3’-磷酸腺苷5’磷酸)转化为AMP(腺苷5’-磷酸)。BPNT1在大脑和肾脏中普遍表达,被锂有效抑制,锂是一种用于治疗躁狂抑郁和双相情感障碍的药物,提示BPNT1可能在情绪障碍的病因中发挥作用。对bpnt1的抑制导致pap的积累和随后对硫转移酶的抑制,这可能导致基因表达的改变、磷脂酰肌醇第二信使功能的改变和/或硫酸化过程的改变。
功能:
将3’-磷酸5’-磷酸腺苷(PAP)转化为5’-磷酸腺苷(APS),将3’-磷酸腺苷5’-磷酸(PAP)转化为AMP。对肌醇1,4-二磷酸(INS(1,4)p2)和肌醇1,3,4-三磷酸(INS(1,3,4)p3的活性降低1000倍,但不水解INS(1)p、INS(3,4)p2、INS(1,3,4,5)p4或INSp6。
组织特异性:
在肾脏、肝脏、胰腺和心脏中高度表达。在脑、胎盘、肺和骨骼肌的较低水平检测。
相似性:
属于肌醇单磷酸酶家族。
重要提示:
本产品仅用于研究用途,不用于人类、治疗或诊断应用
组织/细胞:小鼠肾组织;4%多聚甲醛固定石蜡包埋;
抗原提取:柠檬酸缓冲液(0.01M,pH 6),15min煮沸,用3%过氧化氢阻断内源性过氧化物酶30min;37℃下阻断缓冲液(正常山羊血清)20 min;
孵育:抗bpnt1多克隆抗体,未结合1:200,4°C下过夜,然后与二级抗体结合,DAB染色。
公司优势:
1)质量:我司提供的的试剂为世界。
2)价格:价格实惠,量大从优。
4)服务:提供完整的售前、售后和售中服务。售后到底。
如需订购二磷酸3核苷酸酶抗体(BPNT1),请联系我们。
| Anti-ITG-α5/CD49e(Integrin α5) 粘附分子整合素α5抗体 |
| Anti-ITG-β3/CD61(Integrin β chain,β3 precursor) 整合素-β3抗体 |
| Anti-JNK1/3 (c-Jun amino-terminal kinase 1/3) c-Jun氨基末端激酶1/3抗体 |
| Anti-KATPC (ATP-Sensitive K+ Channel Subunits uKATP-1—ATP) ATP敏感性钾通道蛋白抗体 |